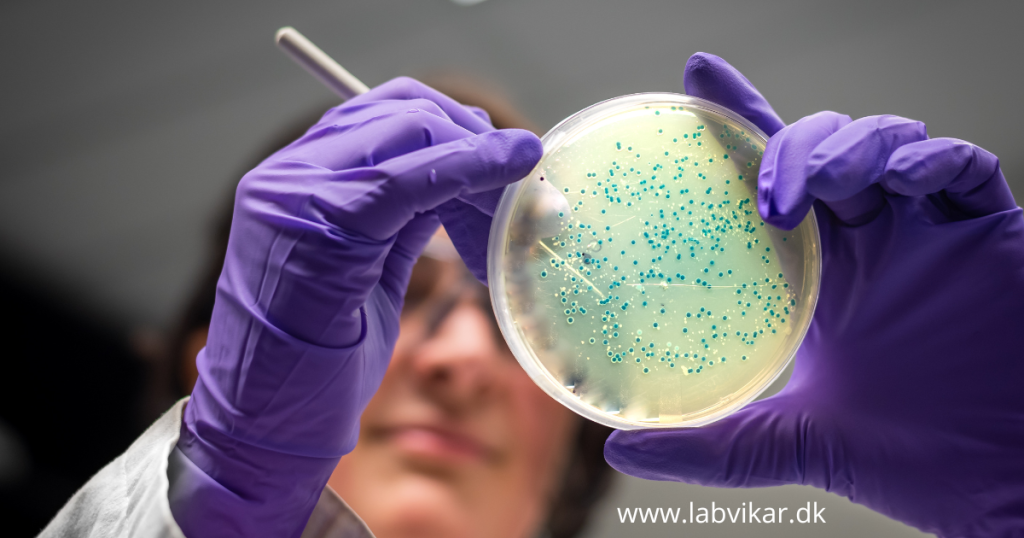

BESAT: Laborant
BESAT: Laborant-vikar søges til analysearbejde 10 timer om ugen i Ikast-Brande Kommune. Der er tale om 5 timers arbejde om dagen i 2 dage om ugen med fleksibel placering af disse. Laborantopgaverne består af analyser jf. kundens egenkontrolprogram: PCA, for totalkim, gær/skimmel og Koli med udsåning, aflæsning samt sensoriske tests etc. Der vil være oplæring […]
Laborant eller lign.

Laborant eller lignende til Brande Vi søger en laborant eller lign. til et vikariat på ca. 3-5 måneder med muligheder for forlængelse. Stillingen ønskes besat hurtigst muligt Arbejdsopgaver: -Udtage råvandsprøver både på fabrikken og på anden lokation. Så kørekort er en nødvendighed. -Modtagelse og udpakning af varer -Mikrobiologiske analyser ved filtrering og dybdeudsåning -Kemiske analyser […]
BESAT: Laborant

BESAT: Vi søger en laborant til vikariat 2 dage om ugen ca. 15 km. nord for Aarhus De primære opgaver drejer sig om mikrobiologiske analyser på råvare, færdigvarer og produktionsmiljø. Kandidat Uddannet laborant Har min. 1-3 års erfaring i et laboratorium der udfører rutinemæssige mikrobiologiske analyser (totalkim, coliforme, gær/skimmel). Erfaring inden for fødevarebranchen eller fødevarerelaterede […]
BESAT: Laboratorie medarbejder

BESAT: Vi søger nu en laboratorieassistent eller lignende til virksomhed belliggende lidt nord for København. Stillingen er et vikariat på fuld tid i 4-6 måneder. Du skal kunne begå dig i et et laboratorium og ikke være bange for kemi/kemikalier, eller for at lære nyt. Du skal være flydende i engelsk i skrift og tale […]
BESAT: Laborant

BESAT: Vi søger en laborant til vikariat 2 dage om ugen ca. 15 km. nord for Aarhus De primære opgaver drejer sig om mikrobiologiske analyser på råvare, færdigvarer og produktionsmiljø. Kandidat Uddannet laborant Har min. 1-3 års erfaring i et laboratorium der udfører rutinemæssige mikrobiologiske analyser (totalkim, coliforme, gær/skimmel). Erfaring inden for fødevarebranchen eller fødevarerelaterede […]
BESAT: Laborant – Frederikssund

BESAT: Laborant til virksomhed i Frederikssund Vi søger for vores kunde en laborant til et 3 måneders vikariat på fuld tid. Der kan være mulighed for forlængelse af vikariatet. Vi ønsker en laborant, som kan starte med det samme. Har du erfaring indenfor elementær mikrobiologi – udsåning, dybdeudsæd, udtagning af prøver i produktionen, svaberprøver, vandprøver, […]
BESAT: Laborant

BESAT: Laborant til Vestsjælland LabVikar søger en erfaren laborant til vores kundes driftslaboratorie. Du vil blive en del af et team, der arbejder tæt sammen med produktionen for at sikre kvaliteten af produkterne. Din profil: Minimum 2 års praktisk erfaring i et driftslaboratorie (ikke nyuddannet). Ikke bange for at tage fat og hjælpe til, hvor der […]
BESAT: Laborant – Midtjylland

BESAT: Laborant til Midtjylland LabVikar søger for kunde en laborant til et vikariat. Virksomheden ligger ca. 30 km. syd for Randers. Vikariatet strækker sig fra uge 30 til 35, 2 dage om ugen med arbejdstid mandage og onsdage fra kl. 08.00 – 12.00 begge uger inkl. Vi ønsker en laborant, som har et par års […]
BESAT: Laborant til Fredericia

BESAT: LabVikar søger for kunde en laborant til Fredericia. Stillingen er et vikariat på fuld tid i uge 25-28 og igen i uge 31 – ca. en måned frem. Mødetid er klokken 7-15 og fredag 7-14.30. Virksomheden er lukket i uge 29+30 Arbejdsopgaver for vikaren vil blive neddeling af råvare Bestemmelse af kornstørrelse-fordeling (sigtekurver) Evt. […]